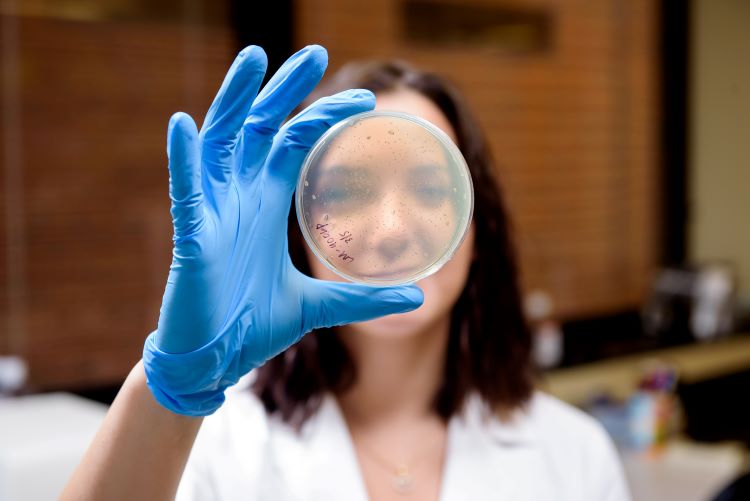

We are recognized leaders for excellence in pathology research, training, and clinical services.
Our faculty take pride in training the next generation of researchers and clinicians, and we are investing in cutting-edge training programs for graduate students, residents, and fellows to prepare them for success as thought leaders in pathology.
We're comprised of eight divisions: Anatomic Pathology, Community Practice Pathology Program, Forensics, Genomic Diagnostics and Bioinformatics, Laboratory Medicine, Molecular & Cellular Pathology, Neuropathology, and Women's Health. We also offer fellowships in Forensic Pathology, Hematopathology, Blood Banking/Transfusion Medicine, Surgical Pathology, Cytopathology, Neuropathology, Dermatopathology, and Molecular Genetic Pathology.
Please visit our news page to learn about the latest discoveries and activities in our robust department. Thank you for visiting and we look forward to hearing from you soon.